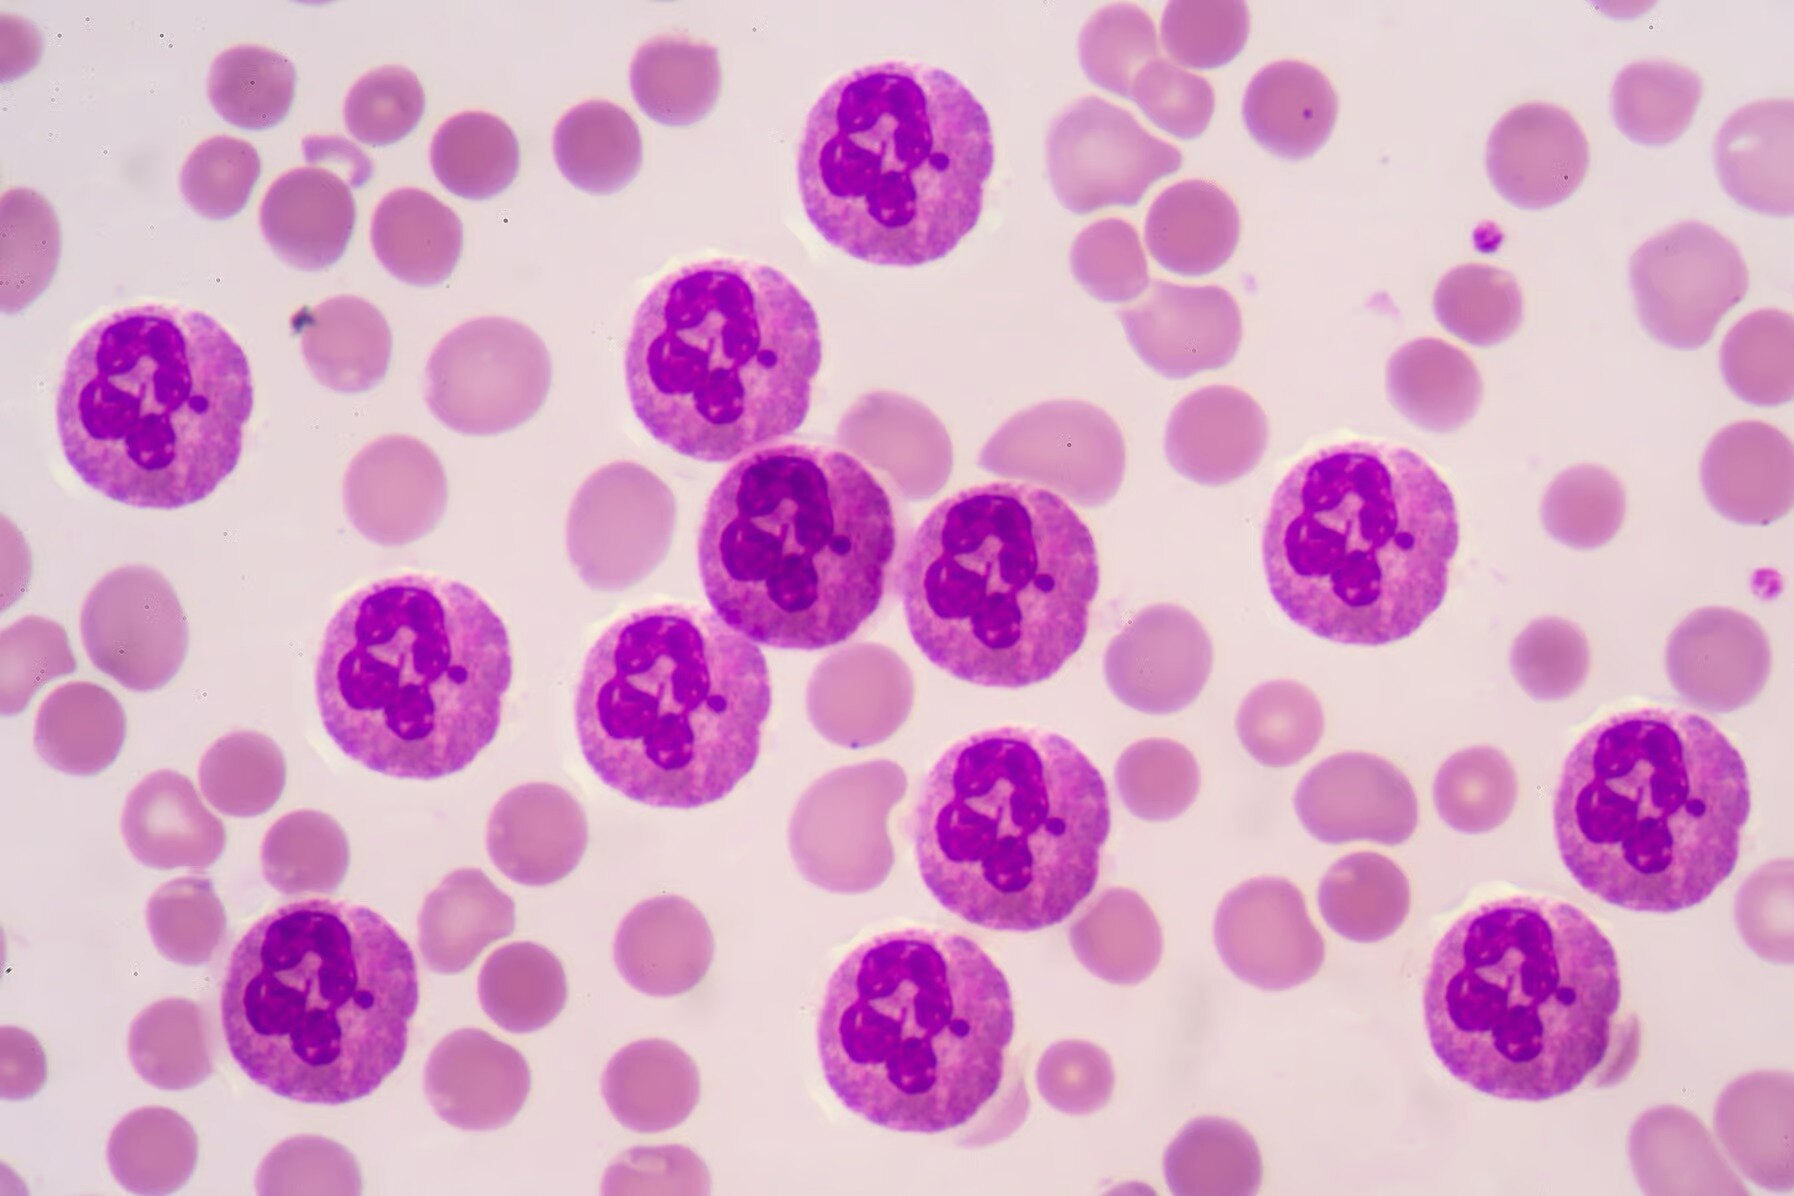
10516e5bceac37a1ca0687f62874b11f_ce_1794x1196x0x0.jpg

Стали известны новые пугающие подробности того, как токсичные соединения PFAS влияют на иммунную систему человека
Негативное воздействие химических веществ, называемых PFAS, на здоровье продолжает оставаться открытым вопросом. Ученые из Университета штата Северная Каролина (NCSU) показали, что некоторые типы PFAS могут нарушать жизненно важные функции иммунных клеток.
Пер- и полифторалкильные вещества (ПФАВ или англ. PFAS) представляют собой широкую группу химических веществ, которые становятся все более и более проблемными по мере того, как ученые получают все больше информации в рамках новых исследований ним. Эти вещества были разработаны в 1940-х годах, и для своего времени это был прорыв: их антипригарные и водоотталкивающие свойства сделали их привлекательными для широкого круга применений в обычных бытовых товарах.
Только позже их влияние на здоровье стало очевидным. Воздействие PFAS было связано, среди прочего, с диабетом, низким весом при рождении, проблемами с фертильностью, заболеваниями щитовидной железы и различными видами рака. Хуже того, их долговечность и обилие делают нас чрезвычайно уязвимыми к воздействию токсинов.
